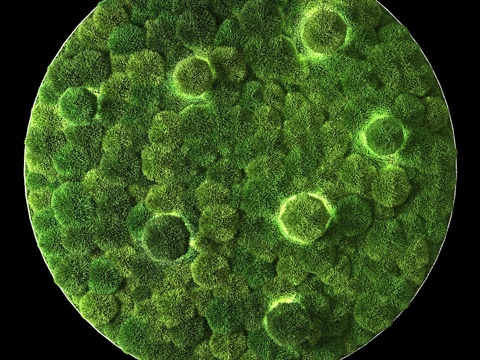
带LED苔藓环3d模型

植物墙 绿植墙3d模型
-
版本详情
:
max2014
转版本 ? -
渲染器
:
CR5.0 -
灯光
:
无灯光
-
上传时间
:
2023-08-15
-
文件大小
?
:
27.83MB

小欧设计库
素材管理工具



 品牌模型
品牌模型

 小O社区
小O社区